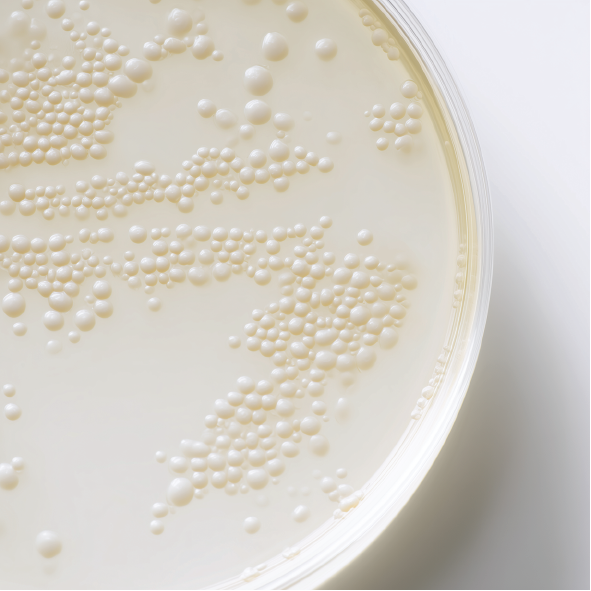

INGREDIENTS & BENEFITS
The Six Core Systems of Longevity
MD1 was designed to target the biological systems most critical for your pets long-term health.
Explore how each ingredient supports six core systems of longevity.

Immune Defense
Immune Defense System


Joint Mobility
Joint Mobility System


Gut Health
Gut Health System


Cognitive & Heart
Cognitive & Heart System


Stress Resilience
Stress Resilience System


Cellular Vitality
Cellular Vitality System

Immune Defense System

Powered by beta-glucans, colostrum, and adaptogens, this formula provides comprehensive immune support for dogs and cats at the cellular level. It helps your pet respond more effectively to daily stressors while protecting long-term vitality — keeping them resilient through every season.

Bovine Colostrum
Bovine Colostrum

Source: First milk from pasture-raised cows; freeze-dried pale yellow powder
Nutrients: Immunoglobulins (≥10%), protein, fat (10.6%), micronutrients
Function: Supports immune defense, tissue repair, gut lining integrity, and healthy skin
Studies: Colostrum and its benefits: a review (ScienceDirect
Links to Studies: https://www.sciencedirect.com/science/article/abs/pii/S0271531702003731

Larch Arabinogalactan
Larch Arabinogalactan

Source: Extracted from wood of the Larch tree; fine powder screened through 60 mesh
Nutrients: Arabinogalactan fiber (soluble), polysaccharides
Function: Prebiotic that feeds beneficial gut flora, modulates immune response via macrophage and NK cell activityStudies: Larch Arabinogalactan: Immune enhancing Polysaccharide (PubMed)
Links to Studies: https://pubmed.ncbi.nlm.nih.gov/10231609/

Maitake Mushroom
Maitake Mushroom

Source: Whole mushroom powder (fruiting body only)
Nutrients: Beta-glucans, polysaccharides, ergosterol
Function: Immunomodulatory, antioxidant, neuroprotective, potential anti-tumor
Studies: Maitake Mushroom Review (PMC)
Links to Studies: https://www.ncbi.nlm.nih.gov/pmc/articles/PMC11068609/

Turkey Tail Mushroom
Turkey Tail Mushroom

Source: Fruiting body powder
Nutrients: Beta-glucans, polysaccharides
Function: Supports immune resilience and gut health via prebiotic action
Studies: NCBI - Turkey Tail & gut microbiota
Links to Studies: https://www.ncbi.nlm.nih.gov/pmc/articles/PMC8572102/

Quercetin
Quercetin

Source: Plant-derived flavonoid extract from Sophora japonica flower buds
Nutrients: Quercetin (flavonol), polyphenols
Function: Anti-inflammatory, antioxidant, natural antihistamine, cardio support
Studies: Recent Advances in Quercetin Benefits (PMC)
Links to Studies: https://www.ncbi.nlm.nih.gov/pmc/articles/PMC10384403/
Joint Mobility System

Marine nutrients from green-lipped mussel and collagen-rich bone broth cushion joints, reduce inflammation, and promote flexibility — offering natural joint health support for pets. Your dog or cat stays agile, active, and pain-free — from playful leaps to daily adventures by your side.

Glucosamine
Glucosamine

Source: Extracted from crustacean shell chitin; powder formNutrients: Glucosamine sulfate (amino sugar)
Function: Joint support — slows cartilage degradation, reduces inflammation, alleviates osteoarthritis symptoms
Studies: Effectiveness of Glucosamine in Osteoarthritis (PMC)
Links to Studies:
https://www.ncbi.nlm.nih.gov/pmc/articles/PMC10366893/

Chondroitin
Chondroitin

Source: Cartilage of bovine origin; white free-flowing powder
Nutrients: Chondroitin (glycosaminoglycan) sulfate
Function: Supports cartilage structure, reduces joint pain, may slow progression of osteoarthritis
Studies: Chondroitin Osteoarthritis (PMC)
Links to Studies: https://www.ncbi.nlm.nih.gov/pmc/articles/PMC4717399/

MSM
MSM

Source: Science derived compound; white crystalline powder
Nutrients: Sulfur (organic form)
Function: Reduces inflammation and joint pain, aids skin repair, supports detox pathways
Studies: MSM Applications & Safety (PMC)
Links to Studies: https://www.ncbi.nlm.nih.gov/pmc/articles/PMC5372953/

Green-Lipped Mussel
Green-Lipped Mussel

Source: Freeze-dried whole mussel powder
Nutrients: Omega-3s (ETA, EPA, DHA), glucosamine, chondroitin
Function: Anti-inflammatory joint support, cartilage nourishment
Studies: GLM and osteoarthritis in dogs
Links to Studies: https://www.ncbi.nlm.nih.gov/pmc/articles/PMC8298224/

Collagen peptides (via Bone Broth) – structural support for joints
Collagen peptides (via Bone Broth) – structural support for joints

Source: Dehydrated broth, slow simmered
Nutrients: Collagen, glycine, calcium, phosphorus, magnesium
Function: Joint, skin & digestive support
Studies: NIH - Nutritional profile of bone broth
Links to Studies: https://www.ncbi.nlm.nih.gov/pmc/articles/PMC6893750/
Gut Health System

Digestive superfoods like pumpkin and prebiotic fibers balance the microbiome and strengthen the gut lining — supporting a healthy pet gut microbiome. The result is smoother digestion, better nutrient absorption, and less bloating — helping your dog or cat feel light, regular, and comfortable every day.

Probiotic Blend
Probiotic Blend
Source: Fermented cultures, spray dried probiotic blend with CFU guarantee (1B CFU per serving)
Nutrients: Live bacteria strains; promotes SCFA (short-chain fatty acid) production
Function: Supports healthy gut flora, strengthens immune response, improves stool quality
Studies: Mechanisms and Benefits of Probiotics (PMC)
Links to Studies: https://www.ncbi.nlm.nih.gov/pmc/articles/PMC10470842/

Pumpkin Powder
Pumpkin Powder

Source: Freeze-dried whole pumpkin powder
Nutrients: Vitamins A, C, E, beta-carotene, fiber
Function: Digestive health, stool consistency, antioxidant immune support
Studies: Pumpkin as a Functional Food (ScienceDirect)
Links to Studies: https://www.sciencedirect.com/science/article/pii/S1658077X21000310

Bone Broth
Bone Broth

Source: Dehydrated broth, slow simmered
Nutrients: Collagen, glycine, calcium, phosphorus, magnesium
Function: Joint, skin & digestive support
Studies: NIH - Nutritional profile of bone broth
Links to Studies: https://www.ncbi.nlm.nih.gov/pmc/articles/PMC6893750/

Taurine
Taurine


Larch Arabinogalactan
Larch Arabinogalactan

Source: Extracted from wood of the Larch tree; fine powder screened through 60 mesh
Nutrients: Arabinogalactan fiber (soluble), polysaccharides
Function: Prebiotic that feeds beneficial gut flora, modulates immune response via macrophage and NK cell activityStudies: Larch Arabinogalactan: Immune enhancing Polysaccharide (PubMed)
Links to Studies:https://pubmed.ncbi.nlm.nih.gov/10231609/
Cognitive & Heart System

Nutrients like nicotinamide riboside, antioxidants, and omega-rich compounds support energy metabolism and protect heart and brain cells — delivering advanced brain and heart health support for pets. Expect sharper focus, steadier energy, and lasting protection against age-related decline.

Taurine
Taurine


CoQ10
CoQ10

Source: Liposomal CoQ10 for enhanced bioavailability
Nutrients: Coenzyme Q10
Function: Cellular energy production, antioxidant protection for heart & brain
Studies: Study - CoQ10 & cardiovascular health in dogs
Links to Studies: https://pubmed.ncbi.nlm.nih.gov/17939577/

Nicotinamide Riboside
Nicotinamide Riboside

Source: Science-derived nicotinamide riboside chloride (powder)
Nutrients: NR (precursor to NAD+), Vitamin B3 family
Function: Cellular energy metabolism, DNA repair, longevity via NAD+ boosting
Studies: NR Research and Therapeutic Uses (PMC)
Links to Studies: https://www.ncbi.nlm.nih.gov/pmc/articles/PMC7352172/
Stress Resilience System

Adaptogenic botanicals like Ashwagandha (KSM-66®) and fruiting-body mushrooms help regulate cortisol and calm overactive pathways — creating a natural stress relief and calming supplement for pets. The result: steady mood, balanced energy, and a pet that feels relaxed, secure, and ready to play.

Ashwagandha
Ashwagandha

Source: Full-spectrum root extract (KSM 66), organic certified
Nutrients: Withanolides, alkaloids
Function: Adaptogen — reduces stress and anxiety, supports sleep, boosts immunity
Studies: Ashwagandha Healthcare Review (PubMed)
Links to Studies: https://pubmed.ncbi.nlm.nih.gov/32242751/

Turkey Tail Mushrooms
Turkey Tail Mushrooms

Source: Fruiting body powder
Nutrients: Beta-glucans, polysaccharides
Function: Supports immune resilience and gut health via prebiotic action
Studies: NCBI - Turkey Tail & gut microbiota
Links to Studies: https://www.ncbi.nlm.nih.gov/pmc/articles/PMC11068609/ & https://www.ncbi.nlm.nih.gov/pmc/articles/PMC8572102/

Maitake Mushroom
Maitake Mushroom

Source: Whole mushroom powder (fruiting body only)
Nutrients: Beta-glucans, polysaccharides, ergosterol
Function: Immunomodulatory, antioxidant, neuroprotective, potential anti-tumor
Studies: Maitake Mushroom Review (PMC)
Links to Studies: https://www.ncbi.nlm.nih.gov/pmc/articles/PMC11068609/
Cellular Vitality System

Collagen-boosting compounds and antioxidant-rich mushrooms shield cells from oxidative stress and restore skin integrity — providing nutrient-dense skin and coat support for dogs and cats. Expect a glossy coat, reduced irritation, and whole-body vitality that radiates through their appearance.

Biotin
Biotin

Source: Powdered crystalline form
Nutrients: Vitamin B7 (5 mcg per serving)
Function: Supports coat, skin, and nail health; aids metabolism and glucose control
Studies: Biotin and Hair Loss (PMC)
Links to Studies: https://www.ncbi.nlm.nih.gov/pmc/articles/PMC5582478/

MSM
MSM

Source: Science derived compound; white crystalline powder
Nutrients: Sulfur (organic form)
Function: Reduces inflammation and joint pain, aids skin repair, supports detox pathways
Studies: MSM Applications & Safety (PMC)
Links to Studies: https://www.ncbi.nlm.nih.gov/pmc/articles/PMC5372953/

Bone Broth
Bone Broth

Source: Dehydrated broth, slow simmered
Nutrients: Collagen, glycine, calcium, phosphorus, magnesium
Function: Joint, skin & digestive support
Studies: NIH - Nutritional profile of bone broth
Links to Studies: https://www.ncbi.nlm.nih.gov/pmc/articles/PMC6893750/

CoQ10
CoQ10

Source: Liposomal CoQ10 for enhanced bioavailability
Nutrients: Coenzyme Q10
Function: Cellular energy production, antioxidant protection for heart & brain
Studies: Study - CoQ10 & cardiovascular health in dogs
Links to Studies: https://pubmed.ncbi.nlm.nih.gov/17939577/


